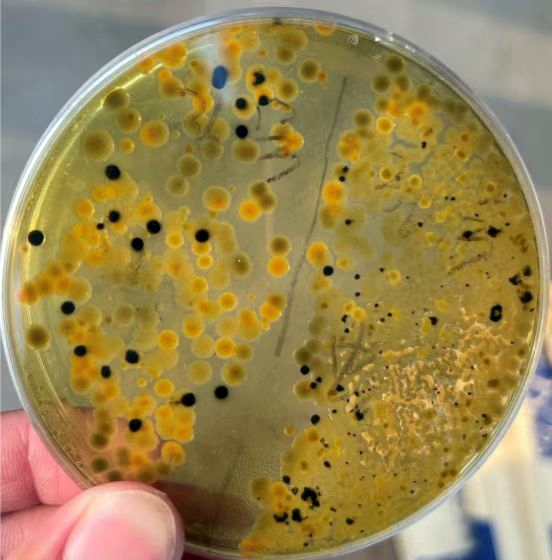

一、水体中硫化氢的危害:
硫化氢(H₂S)是一种可溶性的有毒气体,带有臭鸡蛋气味。当养殖水体中含H₂S约0.2mg/L就可使健康的鱼中毒停食,高于0.5mg/L时引起大批量死亡,在虾蟹育苗水体中危害较为严重,含0.2mg/L的H₂S即引起轻度死亡。在甲壳动物硫化氢中毒机制的研究中发现,硫化氢会影响甲壳动物的中枢及外周神经,影响运动和平衡。硫化氢也可以与对虾血液中的血蓝蛋白结合,降低与氧气的亲和能力,从而使对虾出现缺氧症状。
二、判断硫化氢超标的方法主要包括以下几个方面:
1、生物反应:
鱼虾蟹等养殖物大量活跃在上层水体中,生理性排斥下层水体,部分还表现有厌食、骚动不安、在水体表层游走,大量游塘、跳塘、鳃发黑、游泳足和步足先发黄后发黑,严重时出现大量死亡。



2、气味判断:
硫化氢具有强烈的臭鸡蛋味,在下风口闻到此味,打开增氧机气味加重,可能是硫化氢超标的信号。
3、底泥颜色和臭味:
塘口底泥呈现黑色,气温呈现“臭鸡蛋”的臭味,这些都是硫化氢超标的明显特征。


4、检测
取带底泥水样,通过TCBS琼脂平板检查细菌计数,正常弧菌将显示为绿色或黄色菌落,硫酸盐还原细菌将显示为黑色菌落。或使用硫化氢检测试剂。
三、水产养殖中硫化氢的产生主要与以下几个因素有关:
1、在养殖水体中,剩余的饵料、粪便以及死亡的动植物残渣富含蛋白质、油脂、碳水化合物等营养物质,这些物质为微生物提供了丰富的繁殖环境。当耗氧速率大于复氧速率,且水动力不足时,厌氧微生物能够将含硫蛋白质分解产生大量硫化氢和氨等臭味气体。
2、海水、土壤岩层和高硫燃煤地区的雨水及地下泉水中含有大量的硫酸盐,这些硫酸盐在厌氧条件下被还原为硫化氢
三、硫化氢的防治:
1、提高溶氧:硫化氢在低氧环境下容易积累,所以通过使用增氧机和氧片增加水体中的氧气含量,抑制厌氧菌的生长和繁殖,从而降低硫化氢的产生。
2、改底:池塘底质中的硫酸盐和有机硫化物是产生硫化氢的原料,降低池塘底质中的这两类物质可以有效降低硫化氢的产生,使用超强底改在水中快速释放氧化性强的新生态臭氧,快速氧化池底,抑制水体和底质的有害微生物,改善池底发黑、发臭、底热等不良情况,定期清除池塘中的多余沉积物。

使用前:

使用后:

3、调节水的pH值:使用生石灰消毒通过提高水体的酸碱度,降低硫化氢的毒害作用,但需注意避免过高的pH值导致氨中毒。


4、减少水体中硫的来源:通过科学投喂饲料,减少水体中有机质的积累,从而降低硫化氢产生的可能性。
5、调节水:使用中仁超浓缩粪硫菌,高效下沉性硫氧化菌株,能够迅速分解硫化物,防止其在环境中积累,从而通透底部污泥,消除池底腥臭味,增强塘底自净能力,长期使用可有效改善底泥的颜色和臭味,可以有效地控制和消除水产养殖中的硫化氢问题。

使用前:

使用后:

本文供稿:刘帅,杨光
编辑审核:张传宝,吕钊青,臧学运

